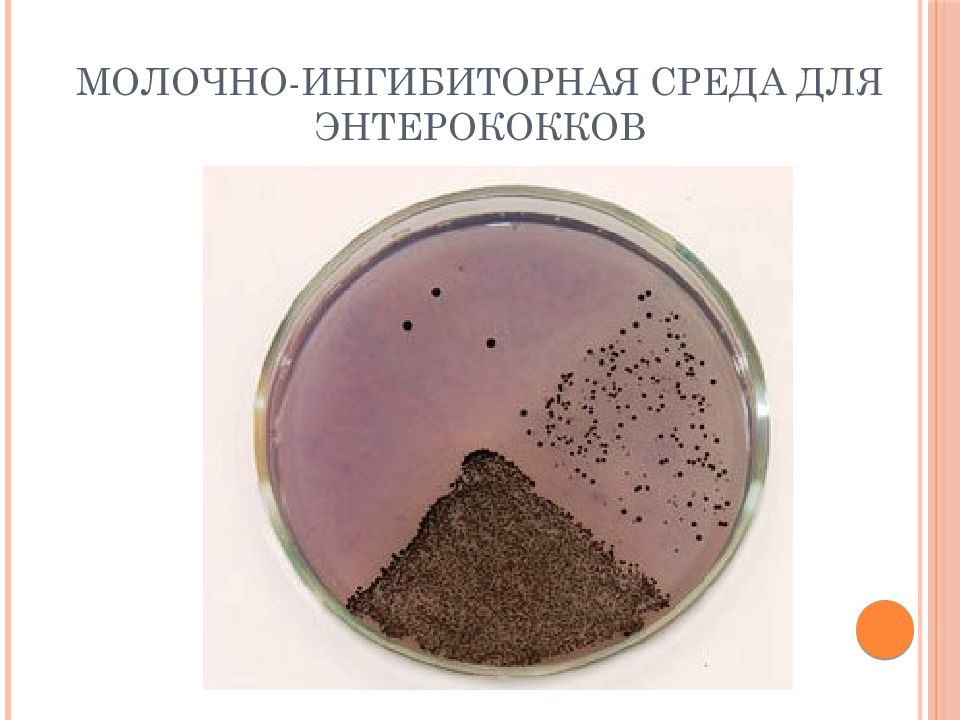

Среда сланец
Black eyebrows
Алиса найди корону
Понятие норма психического развития
Шимохин восхождение язычника 6
Сайлентблок переднего рычага ваз 2114
Demo version песни
Демократический лидер функции
Сколько пуль выпускает
Мой видящий брат
Поздравления учителям 9 класс
Анализы на тестостерон у мужчин спб
Эналаприл импортный или отечественный
С победой на куликовом поле
Среда сланец 84 фотографий